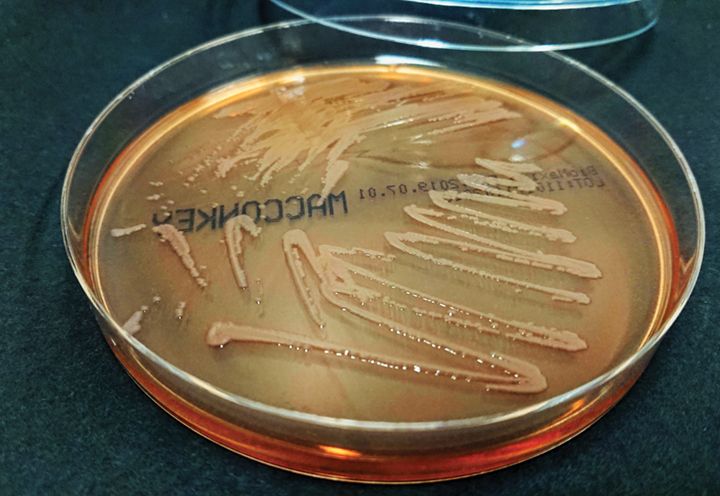

For many infection preventionists (IPs), hand hygiene in healthcare facilities is often subpar. National compliance rates tend to fall well under 50% and even with interventions, sustainable improvement is a unicorn IPs are always in search of.


For many infection preventionists (IPs), hand hygiene in healthcare facilities is often subpar. National compliance rates tend to fall well under 50% and even with interventions, sustainable improvement is a unicorn IPs are always in search of.

A case of 12 one-ounce bottles was being sold by one lister for $3,892.84, which equals just over $324 per ounce.

About 20% of passengers in an airport have clean hands. If that increases to 30%, a potential infectious disease would have a worldwide impact that is about 24% smaller.
Bug of the Month helps educate readers about existing and emerging pathogens of clinical importance in healthcare facilities today.

Sustainability of high hand hygiene rates is extremely challenging and continuously requires resources and substantial effort.


In this uncertain time of constantly changing news and updates that often stress response efforts, it is important to focus on opportunities for prevention and ensuring staff have the right information.

Bug of the Month helps educate readers about existing and emerging pathogens of clinical importance in healthcare facilities today.

Hand hygiene ambassadors in the lobbies of healthcare institutions are a big hit.


Can silver-coated screens on resident physicians’ cell phones reduce microbial contamination?



Bug of the Month helps educate readers about existing and emerging pathogens of clinical importance in healthcare facilities today.










